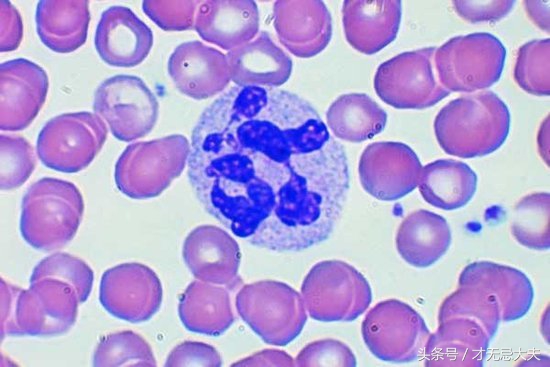
夏天是尿路感染的高发季，如何预防和治疗呢？

才无忌大夫:内科副主任医师,从事临床工作三十多年,全科医师,执业药师。在《*今条头日**》做一名健康知识传播者。如果文章对您有用,记得点右上角↗↗+关注哟。
才无忌大夫友情提示:本文旨在传播健康知识,不作诊断及治疗依据。

泌尿系统示意图
夏天是尿道感染,尿结石疼痛发作的多发季,这与出汗增多和小便量相对减少非常相关。
尿路感染(urinary tract infection),简称尿感。
小编得闲,在此说说尿路感染。
一,哪些人容易患上尿感?
1,育龄妇女
育龄妇女尿路感染相对多见,发病率>5%,其发病率随年龄增加。尿道短,妊娠,*生活性**,口服避孕药等原因,使其更容易患病,同年龄段男女患病率比1:8。

妊娠易患上尿路感染
才无忌大夫提示:妊娠尿感增多是由于输尿管活动减弱,膀胱输尿管反流,妊娠子宫压迫输尿管。*生活性**可以把尿道口等处细菌挤压进膀胱(正常膀胱无菌)。以壬苯聚醇为主要成分的局部避孕药破坏阴道微生物环境,易于诱发尿感。
2,有膀胱输尿管反流者

膀胱输尿管连接处的括约肌
大于90%上尿道感染,是细菌经膀胱上行感染所致。而膀胱输尿管连接处的括约肌对防止尿液反流至关重要。
3,糖尿病患者

控制血糖防止尿感
糖尿病易于感染。在临床上,糖尿病合并尿路感染患者非常多。小便中含糖量高,泌尿系抗病力下降等是其原因。
4,尿路梗阻,畸形等患者

尿结石
包皮过长,尿结石,先天畸形,前列腺肥大等便于细菌定植,上行感染。男性>60岁,尿路感染发病率升高,特别有前列腺肥大者,尿路感染发病率约7%。
5,行泌尿道医疗器械检查及留置导尿管者。

导尿管
保留导尿管易引起导管相关性尿感,原因是给了细菌生长的“根据地”。据权威数据提示:第一天尿感 百里挑一;第二天,二有其一;第三天,十有其九。
6,免疫力低下者,老年人。
感染与否,是细菌和宿主在“较劲”,看谁占上风。
7,遗传易感性患者
尿感也呈现遗传易感性,家族聚集性。
也就是说有些人天生容易患上尿路感染。
以上这些人,对尿路感染的防治,显得非常重要。

尿路感染(尿感)
二,引起尿感的病原体
1,引起尿感的细菌及其他微生物很多,约85%的尿感由大肠杆菌感染引起,普通防治的重点在此。
大肠杆菌是人体的共生菌,大部分与人和谐相处,只有少部分在人体免疫力低下情况下致病。
大肠杆菌非常小,只有千分之一毫米左右,显微镜下可见:

大肠杆菌(大小约1微米)
2,5~15%由肠球菌及凝固酶阴性的葡萄球菌等革兰氏阳性细菌。
3,其他还有克雷伯氏杆菌,支原体,衣原体等,较少。
4,少见尿感中,
金葡菌则由血行传播而来。应当有他处原发灶。
腺病毒可以引起儿童和一些年轻人急性出血性膀胱炎,甚至有流行性。

腺病毒
腺病毒可引起:呼吸系统感染,咽结膜炎热,出血性膀胱炎等,也是麻烦的主。
总之,尿感是以大肠杆菌等革兰氏阴性杆菌感染为主。
才无忌大夫提示:近年耐药菌不断增加。少见菌引起的尿感有增多趋势,此点是医生应该关注的问题。由于高耐药性不建议单独用阿莫西林和第二代头孢(如头孢呋辛)。

三,人体对抗尿路感染有哪些招?
1,尿液的冲洗及杀菌作用
正常泌尿道,平滑肌的收缩及括约肌的舒张很协调,加上足够的尿量,起到对泌尿系的冲洗作用。
尿液中的高尿素,高渗透压,低PH值等,有一定的杀菌作用。
所以夏天更需要充足饮水,以便发挥尿液的冲洗等作用,防止尿感。
2,白细胞等对病原体的吞噬作用。
白细胞就是人体的“警察部队”,对入侵的病原体等迅速扑杀。白细胞减少或缺陷的人,更容易感染。
附:白细胞图片
中间有蓝色分叶核的是白细胞(大小约20微米)
一个白细胞吞噬几十个大肠杆菌,一起消亡;溶菌酶溶解组织等,产生脓液。
3,分泌型的IgA等对细菌的杀灭作用
属于体液免疫。呼吸道,腺体等也有分泌型的IgA。
4,前列腺的分泌物中有杀菌成分
5,膀胱输尿管连接处的括约肌的抗尿液反流作用
四,尿感(UTI)的分类
- 从时间上来说,尿感分为急性尿感,慢性尿感,6个月以上称为慢性尿感。,
- 从部位上来讲,尿感分为上泌尿道感染(肾,输尿管),以肾盂肾炎为主;下尿道感染(膀胱,尿道),以膀胱炎为主。
- 从有无先天畸形,尿路梗阻,压迫等分为:复杂性尿感和非复杂性尿感。
- 再发性尿路感染:6周以内,同一细菌感染称为尿感复发。6周以后,非同一细菌感染为重新感染。
才无忌大夫认为:复杂性,再发性尿感,医院内感染,尿路器械检查等多由非大肠杆菌感染引起,因为罕见必怪,则处理起来稍显麻烦。

尿路感染(英文版)
五,尿路感染的临床表现
(一)肾盂肾炎
肾盂肾炎在尿感中最为严重,一般需要住院治疗。
1,急性肾盂肾炎
一般有寒战高热等全身中毒症状,有肾区疼痛不适,肾区叩击痛,输尿管压痛点压痛阳性等表现。
血常规白细胞整数及中性粒细胞升高,核左移。小便中见白细胞,红细胞,微量蛋白,管型等。尿镜检可见细菌,中段尿细菌培养阳性等。NAG(N-乙酰-β-D-氨基葡萄糖苷酶)升高(由肾小管分泌)。
急性肾盂肾炎可有肾乳头坏死,肾周围脓肿等并发症。
2,慢性肾盂肾炎
病程大于6个月,B超有肾形态学改变。全身中毒症状,尿路刺激症状等未必典型,容易漏诊。
(二)膀胱炎
膀胱炎在尿感中较为常见。多数可门诊治疗。
急性膀胱炎主要表现为:尿频,尿急,尿痛;而全身症状相对较轻。可见耻骨上膀胱区压痛。
血常规白细胞整数及中性粒细胞升高,核左移。小便中见白细胞,红细胞,微量蛋白等。尿镜检可见细菌,中段尿细菌培养阳性等。
(三)无症状细菌尿
没有尿路刺激症状及全身症状,但尿细菌培养阳性,老年人发病率约50%,数量很多啊!
(四)导管相关性尿路感染
和留置导尿管相关,长时间留置导尿管,尿路感染不可避免。临床表现同急性膀胱炎等。
六,哪些辅助检查便于诊断尿路感染?
1,尿常规
可见尿液混浊,异味,这个自己能发现;
显微镜下可有白细胞尿,血尿,蛋白尿。
尿沉渣镜检白细胞>5个/HP,有利于尿感诊断。
部分尿感患者可有镜下血尿,尿沉渣镜检红细胞>3个/HP,称为均一性红细胞尿;极少数可见肉眼血尿,比如EHEC,腺病毒等感染引起的出血性膀胱炎。
2,白细胞排泄率
留三小时尿液,进行白细胞计数,如>3X10^5/h,为阳性,利于尿感诊断。
3,细菌学检查
清洁中段尿沉渣涂片:高倍镜每一视野>1个细菌,提示尿感。
清洁中段尿细菌定量培养≥10^5/ml,(临床无症状须两次,且为同一菌),称为真性菌尿。注意:1小时内进行培养;膀胱存留时间>6小时。
4,亚硝酸盐还原试验
大肠杆菌等革兰氏阴性菌可使尿中的硝酸盐还原成亚硝酸,如小便中亚硝酸盐阳性,利于尿感诊断。尿液自动分析仪中带此项检查。
5,NAG(N-乙酰-β-D-氨基葡萄糖苷酶)升高可反应肾小管上皮受累。
6,血常规血生化及影像学检查等

血常规血生化可以反应炎症的轻重,肾功能情况;X线及B超可以明确炎症部位,有无尿路梗阻,肾脏形态学变化(便于区分急慢性肾盂肾炎)等。
总体来说,依据尿路刺激症状及尿常规等简易检查基本能诊断出大部分尿路感染。
七,尿路感染的治疗
小编根据治疗时间整理出:
(一),短程疗法(3天)
适用于急性膀胱炎,门诊治疗。
3日短程疗法选用以下抗生素(举例):
SMZco: 2片/1次, 2次/1日,规格为0.48。
左氧: 0.5/1次,1次/1日
阿莫西林:0.5-1.0/1次 ,3次/1日。
头孢呋辛:0.25/1次,2次/1日。
以上药物,根据个人情况选用一种。(妊娠及哺乳期请在医师指导下用药)
停药7天,进行尿培养,阴性算治愈;如果阳性,继续用抗生素2周。
才无忌大夫提示:对于老年患者,糖尿病患者,妊娠妇女,男性患者,免疫功能低下者,不宜选用3日短程疗法,应该选用较长疗程(=或>7日)。

(二)2周疗法(14天)
适用于:
1,急性膀胱炎3日疗法后尿菌仍然阳性的追加治疗;
2,急性肾盂肾炎和慢性肾盂肾炎急性发作,临床表现较轻者。
病情轻者,一般无全身中毒症状,可以选用上述3日短疗程用药,延长疗程至14天(2周疗法),可以两联用药。停药后,尿细菌培养阴性,算治愈;如阳性,依据药敏试验,继续治疗4-6周(2周疗程的2-3倍)。
3,急性肾盂肾炎和慢性肾盂肾炎急性发作,临床表现较重者。
病情重者,需要住院治疗,静脉给药。
选用广谱青霉素,第三代头孢,氟喹诺酮类等,疗程不少于2周,可以联合用药。经验选药+药敏试验选药。注意肾乳头坏死,肾周围脓肿等并发症,保护好肾功能。

(三)4周疗法及6周疗法
适用于:
1,上述急性肾盂肾炎及慢性肾盂肾急性发作2周疗法,尿菌仍然阳性者。酌情使用4周疗法(相对较轻),6周疗法(相对较重)。
2,再发性尿路感染。
治疗后症状消失,尿菌阴性,但在停药6周后再次尿感,且非同一细菌感染称为重新感染,治疗可参照第一次感染;6周以内,且同一细菌感染,称为复发。
依据药敏,选用两联抗生素。

(四)半年疗法
长程低剂量抑菌治疗(半年疗程),即每晚睡前排尿后服用小剂量抗生素1次。
适用于:
1,半年内尿路感染2次及以上.
2,慢性肾盂肾炎。
3,急性肾盂肾炎迁延不愈者。
4,妊娠期尿路感染难愈者。
5,免疫力低下,有诱发感染因素者。
6,慢性尿感伴前列腺肥大者。
长程低剂量抑菌疗法(半年疗程)用药举例:
SMZco:1- 2片/1次,规格为0.48。
左氧: 0.2/1次。
阿莫西林:0.5-1.0/1次 。
头孢呋辛:0.125/1次。
呋喃妥因:50mg-100mg/1次。
治疗后症状消失,尿菌阴性,但在停药6周内再次尿感,而且尿培养细菌和上次尿培养为同一细菌,称为复发。在去除尿路梗阻等诱发因素的前提下,依据药敏试验联合选用抗生素,疗程不少于6周(6周疗法)。反复发作给予长程低剂量抑菌治疗(半年疗法)。
才无忌大夫提示:对于妊娠期尿感,可以选用的抗生素是,阿莫西林,呋喃妥因,头孢菌素;疗程7-14天;可用呋喃妥因行长程低剂量抑菌治疗。参照第8版内科学(人民卫生出版社)。

归纳起来:
一般急性膀胱炎选用3日疗法,单一抗生素。妊娠,男性,糖尿病患者等延长疗程(1周疗程);
肾盂肾炎,轻型选用2周疗法,可以使用两联抗生素,尿菌持续阳性,依照药敏选药,继续6周疗法;重度肾盂肾炎,住院治疗,静脉给药,2周疗法,尿菌持续阳性依照药敏选药,继续4-6周疗法(门诊)。
再发性尿路感染,去除尿结石等诱因,依照药敏选药,疗程2-6周,可以使用长程低剂量抑菌治疗(半年疗法)。
无症状性菌尿,特殊人群需要治疗,可以使用长程低剂量抑菌疗法。
八,预防尿路感染,我们该注意些什么呢?
1,多饮水,勤排尿,是预防尿感最有效方法,尤其在夏天,出汗多小便少时。

2,有膀胱输尿管反流患者,要“两次排尿”,每次排尿后数分钟,再排尿1次。
3,糖尿病者控制好血糖,利于防止尿感。
4,注意会阴局部卫生。

5,与*生活性**有关尿感,事后立即排尿,服一次常用量抗生素。
6,有尿结石者去除结石可减少尿感。
不能去除尿结石者,长程低剂量抑菌治疗。
7,如非必要,避免尿路器械的使用,如使用严格无菌操作。
8,尽量不留置导尿管,如需要留置,尽早拔出。
9,增强体质,提高免疫力。
才无忌大夫注重预防知识的宣传。

观念决定行为